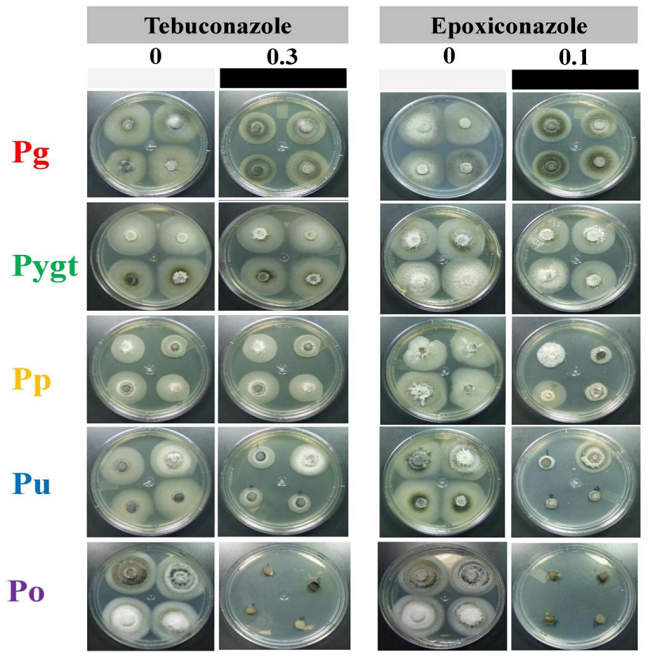
Mycelial growth of isolates from Pyricularia grisea (Pg), P. pennisetigena (Pp), P. urashimae (Pu), P. graminis-tritici (Pygt) and P. oryzae (Po) in potato-dextrose-agar medium (PDA) without fungicide or with 0.3 μg mL-1 tebuconazole or 0.1 μg mL-1 epoxiconazole.

CROP PROTECTION
Resistance to triazole fungicides in Pyricularia species is associated with invasive plants from wheat fields in Brazil
Resistance to triazole fungicides in Pyricularia species is associated with invasive plants from wheat fields in Brazil
Acta Scientiarum. Agronomy, vol. 41, e39332, 2019
Editora da Universidade Estadual de Maringá - EDUEM
Received: 10 September 2017
Accepted: 05 December 2017
ABSTRACT.: Triazole fungicides have not been effective for managing the wheat blast disease in Brazil. A broad analysis across six geographical populations of Pyricularia graminis-tritici in central-southern Brazil indicated a high level of resistance to triazole fungicides. Since P. graminis-tritici is also associated with others poaceous species, here, we analyzed whether triazole-resistant isolates of the blast pathogen could be recovered from other poaceous hosts that are invasive of sprayed wheat fields. In addition to P. graminis-tritici (Pygt), we also evaluated the levels of sensitivity of three other grass-associated blast pathogens, which included P. grisea (Pg), P. pennisetigena (Pp), and P. urashimae (Pu). Resistance to the triazole fungicides tebuconazole and epoxiconazole was assessed phenotypically based on EC50 values and molecularly by analysis of the presence of mutations in the CYP51A gene, which encodes for the target enzyme 14-alpha-demethylase. We detected triazole-resistant Pyricularia spp. (Pg, Pp, Pu and Pygt) that is associated with Avena sativa, Cenchrus echinatus, Chloris distichophylla, Cynodon sp., Digitaria horizontalis, D. sanguinalis, Panicum maximum or Urochloa spp. The major outcome from our study was the evidence that invasive poaceous species from wheat fields could be an important source of triazole resistant fungal inoculum for the initial phases of the wheat blast epidemics.
Keywords: blast disease, CYP51A gene, sterol demethylation inhibitor (DMI) fungicides, epoxiconazole, tebuconazole.
Introduction
Since the late 1980’s, wheat blast has been considered a major disease, causing high yield losses on crops from central-southern Brazil (Maciel, 2011; Maciel et al., 2014). After its first report in 1986 in northern Paraná State, Brazil (Igarashi, 1986), it has rapidly spread to all of the wheat cropping areas of the country as well as to Argentina, Bolivia, and Paraguay (Maciel, 2011). Initially restricted to South America, wheat blast was recently introduced in Bangladesh in Southeastern Asia (Callaway, 2016; Islam et al., 2016).
Management of wheat blast disease is considered particularly difficult due to the inexistence of durable varietal resistance and the lack of effective systemic fungicides (Maciel et al., 2014; Pagani, Dianese, & Café Filho, 2014; Castroagudin et al., 2015). Despite their low efficacy for controlling blast disease on wheat ears, systemic fungicides such as triazoles have been extensively and widely used in Brazilian wheat fields since the 1990’s for managing other fungal diseases, including leaf rust, powdery mildew, leaf spots and gibberella diseases (Navarini & Balardin, 2012; Tormen et al., 2013; Debona, Favera, Corte, Domingues, & Balardin, 2009).
These triazole fungicides have three major active ingredients: epoxiconazole, prothioconazole and tebuconazole (Maciel, Paludo, Silva, Scheeren, & Caierão, 2008). Triazole fungicides belong to the sterol demethylation inhibitor (DMI) group, which is characterized by the inhibition of ergosterol biosynthesis, an important component of the fungal cell membrane (Snelders, Karawajczyk, Schaftenaar, Verweij, & Melchers, 2010). The target of these fungicides is the 14-alpha-demethylase enzyme, which is encoded by the CYP51 gene, a member of the cytochrome P450 family (Zhan, Stefanato, & McDonald, 2006).
The emergence of fungicide resistance could be one of the main causes of the low efficacy of triazole (Ceresini et al., 2018). A strong selection pressure resulting from several years of extensive and frequent applications of triazoles for disease control may have triggered the emergence of resistant pathogen populations (Lucas, Hawkins, & Fraaije, 2015). This scenario of intensive triazole usage leading to the emergence of resistance and reduced fungicide efficacy has been reported in Europe, South America, and Asia for many plant pathogens associated with cereal crops such as Erysiphe graminis on barley and wheat (Buchenauer & Hellwald, 1985) and Mycosphaerella graminicola (Brunner, Stefanato, & McDonald, 2008) and Parastagonospora nodorum on wheat (Pereira, McDonald, & Brunner, 2016).
Resistance to triazoles may be directly related to (1) mutations in the CYP51 gene that encode the target protein resulting in decreased protein affinity for the inhibitors; (2) overexpression of the CYP51 gene, and (3) increased efflux of toxic compounds out of the fungal cell due to overexpression of the gene encoding membrane transport proteins. A combination of these mechanisms is also possible (Cools & Fraaije, 2013).
Mutations in the paralog A of the CYP51 gene (CYP51A) were considered the primary cause for the reduction in sensitivity to triazoles in fungi with multiple CYP51 genes, such as the wheat head blight pathogen Fusarium graminearum (Jiang, Liu, Yin, & Ma, 2011; Fan et al., 2013), the rice blast pathogen Pyricularia oryzae (Yan et al., 2011), and the wheat blast pathogen P. graminis-tritici (Ceresini et al., 2018). In fact, widespread distribution of resistance to the triazole fungicides epoxiconazole and tebuconazole has been reported in populations of P. graminis-tritici from several wheat fields in central-southern Brazil (Ceresini et al., 2018).
Since P. graminis-tritici can also be associated with others poaceous species (Castroagudin et al., 2016), the main objective of our study was to test whether triazole-resistant isolates of the wheat blast pathogen could be recovered from other poaceous hosts that are invasive of triazole-sprayed wheat fields. Since three other blast pathogens (P. grisea, P. pennisetigena, and P. urashimae) were obtained from the sampling of these invasive poaceous hosts in our study, we tested the additional hypothesis that triazole spraying on wheat fields has contributed to and selected for resistance in non-target Pyricularia species.
Up until now, there has been no report of the occurrence of triazole resistance in populations of blast pathogens associated with other poaceous hosts that are invasive of wheat fields in Brazil. Thereby, we evaluated the levels of sensitivity of the blast pathogens P. graminis tritici, P. grisea, P. pennisetigena, and P. urashimae to the triazole fungicides epoxiconazole and tebuconazole. The levels of triazole sensitivity were determined based on the individual EC50 values (the effective concentration that inhibits 50% of mycelial growth). We also analyzed the CYP51A gene for the presence of particular mutations that could be correlated with triazole resistance. Finally, a reticulate phylogeny of the CYP51A gene was built and examined to describe the evolutionary relationships among haplotypes of the Pyricularia species.
Material and methods
Thirty-two isolates of Pyricularia ssp. were used in this study, of which 28 were from blast-diseased poaceous species that are invasive to wheat fields and four from wheat blast. These isolates comprised four Pyricularia species: P. grisea (Pg, N = 4), P. pennisetigena (Pp, N = 4), P. urashimae (Pu, N = 4) and P. graminis-tritici (Pygt, N = 20). These isolates were obtained in 2012 by sampling diseased plants using transect system in Paraná (PR) and Mato Grosso do Sul (MS) and later identified at the species level (Castroagudin et al., 2016; Crous et al., 2016; Reges et al., 2016). In addition, seven isolates of P. oryzae (Po), sampled from rice fields in Goiás (GO) and Tocantins (TO) in 2007, were included as sensitive standards (Table 1).
Two fungicides labeled for managing wheat blast disease in Brazil were selected to assess the resistance of Pyricularia spp. to triazoles: Folicur 200 EC (tebuconazole 200 g L-1, Bayer S.A., Belford Roxo, Brasil) and Tango Cash (epoxiconazole 75 g L-1, BASF S.A., Guaratinguetá, Brasil). For Pg, Pp, Pu, and Pygt, fungicide resistance screening was performed using a dose-response curve that contained the following seven final concentrations: 0.0, 0.0, 0.3, 0.75, 0.9, 1.8, 4.1, and 6.8 µg mL-1 tebuconazole and 0.0, 0.04, 0.10, 0.30, 0.675, 1.0, and 2.0 µg mL-1 epoxiconazole. Dose-response curves for the triazole-sensitive isolates from Po were determined using the following nine final concentrations: 0, 0.003, 0.005, 0,01, 0.02, 0.04, 0.075, 0.150, and 0.3 µg mL-1 tebuconazole and 0.0, 0.0015, 0.0025, 0.005, 0.01, 0.02, 0.04, 0.075, and 0.1 µg mL-1 epoxiconazole.
| Species, isolates | Host | Origin |
| Pyricularia grisea (Pg) | ||
| 12.0.082 | Crabgrass (Digitaria sanguinalis) | Amambai, MS |
| 12.0.264 | Crabgrass (D. sanguinalis) | Aral M., MS |
| 12.0.713 | Jamaican Crabgrass (Digitaria horizontalis) | Londrina, PR |
| 12.0.733 | Jamaican Crabgrass (D. horizontalis) | Londrina, PR |
| Pyricularia pennisetigena (Pp) | ||
| 12.0.046 | Sandbur (Cenchrus echinatus) | Aral M., MS |
| 12.0.102 | Sandbur (C. echinatus) | Amambai, MS |
| 12.0.358 | Guinea grass (Panicum maximum) | Aral M., MS |
| 12.0.408 | Sandbur (C. echinatus) | Aral M., MS |
| Pyricularia urashimae (Pu) | ||
| 12.0.212 | Guinea grass (P. maximum) | Aral M., MS |
| 12.0.224 | Oat (Avena sativa) | Aral M., MS |
| 12.0.561i | Guinea grass (P. maximum) | Londrina, PR |
| 12.0.595i | Weeping finger grass (Chloris distichophylla) | Londrina, PR |
| Pyricularia graminis-tritici (Pygt) | ||
| 12.1.127 | Wheat (Triticum aestivum) | Amambai, MS |
| 12.1.130 | Wheat (T. aestivum) | Amambai, MS |
| 12.1.146 | Wheat (T. aestivum) | Amambai, MS |
| 12.1.150 | Wheat (T. aestivum) | Amambai, MS |
| 12.0.045 | Barnyard grass (Echinochloa crusgalli) | Amambai, MS |
| 12.0.046 | Signal grass (Urochloa brizantha) | Amambai, MS |
| 12.0.231 | Signal grass (U. brizantha) | Aral Moreira, MS |
| 12.0.232 | Signal grass (U. brizantha) | Aral M., MS |
| 12.0.322 | Oats (A. sativa) | Aral M., MS |
| 12.0.347 | Oats (A. sativa) | Aral M., MS |
| 12.0.368 | Signal grass (U. brizantha) | Aral M., MS |
| 12.0.534i | Indian goosegrass (Eleusine indica) | Londrina, PR |
| 12.0.535i | Sandbur (C. echinatus) | Londrina, PR |
| 12.0.555i | Jamaican Crabgrass (D. horizontalis) | Londrina, PR |
| 12.0.572i | Guinea grass (P. maximum) | Londrina, PR |
| 12.0.578i | Star grass (Cynodon spp.) | Londrina, PR |
| 12.0.594i | Oat (A. sativa) | Londrina, PR |
| 12.0.607i | Weeping finger grass (C. distichophylla) | Londrina, PR |
| 12.0.613i | Weeping finger grass (C. distichophylla) | Londrina, PR |
| 12.0.625i | Crabgrass (D. sanguinalis) | Londrina, PR |
| Pyricularia oryzae (Po) | ||
| 662 | Rice (Oryza sativa) | Formoso, GO |
| 364 | Rice (O. sativa) | Lagoa Impacto, TO |
| 623 | Rice (O. sativa) | Lagoa Impacto, TO |
| 630 | Rice (O. sativa) | no data |
| 656 | Rice (O. sativa) | Formoso, GO |
| 662 | Rice (O. sativa) | Lagoa D. Carolina, TO |
| 704 | Rice (O. sativa) | Lagoa Arco Iris, TO |
The fungal inoculum consisted of 5 mm discs obtained from 5-day-old cultures of Pyricularia spp. that were grown on potato-dextrose-agar (PDA) [18 g L-1 of potato-dextrose (Himedia, Mumbai, MA, India) and 15 g L-1 of agar (Himedia), supplemented with chloramphenicol and streptomycin (50 µg mL-1 each)]. The inoculum was transferred to PDA medium supplemented with different concentrations of tebuconazole and epoxiconazole. The fungal mycelial growth was determined after 5 days incubation at 25°C and 12 hours of light, measuring the colony diameters. The EC50 values (effective fungicide concentration, in µg mL-1, capable of inhibiting 50% of mycelial growth) were determined with the program ED50plus v1.0 (Vargas, 2000), according to the procedures described by Ma, Yoshimura, Holtz, and Michailides (2005) with modifications and using the fungicide concentrations converted into log and fungal relative growth data. The experimental design was completely randomized with six repetitions per treatment, and the experiment was replicated once. Analysis of variance and the test for comparisons of means (Scott-Knott at p ≤ 0.05) were performed using the software R and the statistical package Agricolae (R Development Core Team, 2011).
For fungal DNA extraction, the mycelial mass of thirty-nine isolates of Pyricularia spp. was obtained by cultivation in PD broth (potato-dextrose, Himedia, Mumbai, MA, India) for seven days at 24°C and 150 rpm. The DNA was extracted with the GenElute Plant Genomic DNA Miniprep kit (Sigma-Aldrich, USA) according to the manufacturer’s recommendations and quantified using a spectrophotometer NanoDrop® 2000c (Thermo Fisher Scientific, USA).
Seven primers were designed to ensure amplification of the CYP51A gene for all five Pyricularia species that were included in our study (Table 2). For each species, three distinct primer combinations were used in PCR reactions for complete coverage of the CYP51A gene (Additional file 1, Table 2).
| Primer | Sense | Sequence (5’- 3’) | Species a |
| CYP51A_-278F | Forward | CTTTTGTCACTTGTTCTCTGCC | Pg*, Pgt*, Pp*, Pu*, Po* |
| CYP51A_1F | Forward | ATGGCTTTCTTCTTCCCATC | Pgt, Pp, Pu |
| CYP51A_-242F | Forward | TAAATCCCTCTGGCTTAATCGC | Pg, Po |
| CYP51A_662F | Forward | GCCCCATCAACTTCCTAG | Pg*, Pgt, Pu, Po |
| CYP51A_757R | Reverse | TGAGGTCCATGTAAACATCG | Pg, Pgt, Pp, Pu, Po |
| CYP51A_1345R | Reverse | CAAAGGGCAGGTAAGGACTC | Pg, Pgt*, Pp*, Pu*, Po* |
| CYP51A_1749R | Reverse | AGAGATATGCCTCATTGCTAAA | Pg*, Pgt*, Pp*, Pu*, Po* |
Polymerase chain reaction (PCR) was performed in a ProFlex thermal cycler (Applied Biosystems, USA) with a final volume of reaction of 25 µL containing ultrapure distilled water, 50 ng of total fungal DNA, 0.3 µM each primer, 0.2 mM dNTP, 2 mM MgCl2, 2.5 µL of 10X buffer and 1 U of Taq DNA polymerase (Sigma-Aldrich, USA). The following cycling conditions were used: initial denaturation at 95°C for 7 min.; 35 cycles of 95°C for 1 min., 52°C as annealing temperature for 1 min., and 72°C for 1 min.; and final extension at 72°C for 7 min. for Pg, Pp, Pu, and Pygt, while for Po, the annealing temperature was set at 55°C. Amplifications of the DNA fragments were checked on a 1% agarose gel. The sequencing reactions were performed at Macrogen Inc., Seoul, South Korea, using an ABI 3700 DNA analyzer. To obtain total coverage of the CYP51A gene (1551 bp), three sequencing reactions using primers described in Additional file 1 and Table 2 were performed for each isolate, and the fragments obtained were aligned to generate a consensus sequence. The consensus DNA sequences for each isolate were aligned and analyzed using the software Geneious R v. 9.0.5 (Biomatters, Auckland, New Zealand). The complete sequence of CYP51A for Pp, Pu, Pygt, and Po was 1551 bp in length, while for Pg, it was 1420 bp (~92% of gene coverage).
Haplotype frequencies were determined using the program DnaSP version 5.10.1 (Rozas, 2009). The CYP51A gene sequences were checked for synonymous and non-synonymous mutations using as reference the CYP51A gene sequence from Po isolate 622 (with sensitive phenotype for both tebuconazole and epoxiconazole).
The phylogenetic relationships among distinct CYP51A haplotypes were determined by reconstructing a reticulate phylogeny using the parsimonious statistical method implemented in the program TCS version 1.21 (Clement, Posada, & Crandall, 2000). We also build an UPGMA phylogenetic tree using the Geneious R tool Tree Builder, assuming the evolutionary model HKY. The internode support for the branches was tested by bootstrap with 1,000 data resampling.
Results and discussion
Increasing concentrations of the DMI fungicides tebuconazole and epoxiconazole resulted in mycelial growth reduction for all isolates of Pyricularia spp. from different poaceous species (Figure 1; Additional file 2). There were also differences among isolates within species, allowing for the discrimination between extreme DMI-resistant and DMI-sensitive phenotypes in four out of the five Pyricularia spp. examined (Pg, Pp, Pu, and Pygt; Additional file 2). The mean species effect was significant at p ≤ 0.001 for both tebuconazole and epoxiconazole, and the EC50 values were significantly different among Pyricularia species (Scott-Knott at p ≤ 0.05) (Figure 2).
Figure 1
Mycelial growth of isolates from Pyricularia grisea (Pg), P. pennisetigena (Pp), P. urashimae (Pu), P. graminis-tritici (Pygt) and P. oryzae (Po) in potato-dextrose-agar medium (PDA) without fungicide or with 0.3 μg mL-1 tebuconazole or 0.1 μg mL-1 epoxiconazole.

Figure 2
Boxplot representing the variation in EC50 values to DMI fungicides by isolates of Pyricularia spp. The mean EC50 values for isolates of each Pyricularia species with the CYP51A gene sequenced were indicated by a red line a. a A complete randomized experimental design with six repetitions per fungal isolate of each species was used. The experiment was replicated once. Data from the two experiments were combined for the variance analyses because there were no significant differences between experiments (Ftebuconazole experiments = 1.945NS, p = 0.1639; Fepoxiconazole experiments = 3.166 NS, p = 0.0759) and the ranking of species based on their EC50 values was consistent across experiments, indicating no significant interaction. The species effect was significant for both fungicides (Ftebuconazole species = 255.27***, p < 0.001; Fepoxiconazole species = 159.42***, p < 0.001). Five Pyricularia species were compared: P. grisea (Pg, N = 4 isolates), P. pennisetigena (Pp, N = 4) P. urashimae (Pu, N =4), P. graminis-tritici (Pygt, N = 20) and P. oryzae (Po, N = 7). Boxplots followed by the same capital letters indicated no significant differences between species in EC50 values (Scott-Knott test at p < 0.05).
Pygt and Pp were highly resistant to tebuconazole, showing the highest EC50 values (EC50 = 1.438 and = 1.421 µg mL-1, respectively), and significantly different from the other species (p ≤ 0.05). Pu and Pg where also resistant to tebuconazole, but with intermediate EC50 values varying from 0.771 to 1.074 µg mL-1, respectively. In contrast, Po was highly sensitive to tebuconazole, with a very low mean EC50 = 0.036 µg mL-1, which was significantly lower than that of all the other Pyricularia species examined (Figure 2).
For epoxiconazole, Pygt and Pg were highly resistant, with EC50 values varying from 0.357 to 0.445 µg mL-1, respectively, and significantly different from one another (p ≤ 0.05). Pp and Pu showed intermediate EC50 values (= 0.284 and 0.233 µg mL-1, respectively), whereas Po presented the lowest EC50 (= 0.026 µg mL-1), significantly lower than all the other species (p ≤ 0.05) (Figure 2).
From a total of 13 mutations detected along the CYP51A gene from Pp, Pu and Pygt, one was nonsynonymous, while 12 were synonymous. The single nonsynonymous mutation was found at residue 158 of the CYP51A gene with a resulting amino acid change from arginine to lysine R158K (Table 3).
| Haplotype | Species a | Frequency | Tebuconazole Mean EC50 (µg mL-1) | Epoxiconazole Mean EC50 (µg mL-1) | Position (bp) b | 1 | ||||||||||||
| 4 | 4 | 4 | 4 | 5 | 6 | 7 | 9 | 9 | 9 | 0 | ||||||||
| 4 | 7 | 0 | 6 | 7 | 9 | 3 | 7 | 5 | 0 | 2 | 4 | 8 | ||||||
| 2 | 8 | 8 | 2 | 3 | 8 | 4 | 5 | 6 | 6 | 7 | 5 | 3 | ||||||
| H6 | Po | 7 | 0.0357 | 0.0265 | Reference | A | A | A | C | G | C | A | C | C | T | T | G | G |
| Nonsynonymous | * | |||||||||||||||||
| Type of mutation c | t | v | t | t | t | V | t | t | T | v | t | T | T | |||||
| Replacement of aa d | S | I | Q | P | R158K | S | V | F | L | L | S | A | T | |||||
| Mutations | ||||||||||||||||||
| H1 | Pygt | 16 | 1.4381 | 0.3572 | G | C | G | T | A | G | G | T | | G | C | A | A | |
| Pp | 1 | 1.4210 | 0.2849 | G | C | G | T | A | G | G | T | | G | C | A | A | ||
| Pu | 1 | 0.7716 | 0.2326 | G | C | G | T | A | G | G | T | | G | C | A | A | ||
| H7 | Pygt | 1 | 1.4381 | 0.3572 | G | C | G | T | A | G | G | T | T | G | C | A | A | |
| H8e | Pg | 1 | 1.0742 | 0.2849 | G | C | G | G | A | | G | | T | G | C | A | | |
For Pg, in contrast, in addition to the mutation resulting in the R158K substitution, another 51 nonsynonymous mutations were detected. The occurrence of these 52 mutations was possibly related to the phylogenetic distance between Pg and the group that includes the sister species Pp, Pu, and Pygt (Figure 3). In fact, the phylogenetic tree for the CYP51A gene evidenced that the species Pp, Pu, and Pygt shared the identical haplotype H1, which was closely related to H7 but distinct from Po, all with high bootstrap support. In contrast, the clade containing Pp, Pu, Pygt, and Po was only 80.9% similar to Pg (Additional file 3). The reconstruction of a reticulate phylogeny also allowed for the depiction of nucleotide variation within the CYP51A gene, the frequency of occurrence of the haplotypes detected, and their relationships (Figure 4). Four distinct haplotypes were detected: H6 - DMI sensitive, associated exclusively with Po (MF381150) (N = 7); H1 - DMI resistant, which was the most frequent among the haplotypes (N = 18), associated with Pp (MF381153), Pu (MF381152) and Pygt (MF381151), and distinct from H6 by eleven mutational steps; H7 - DMI resistant, which was found only once (i.e., a singleton) in the Pygt isolate 12.0.145 (MF381154); and the haplotype H8 - DMI resistant, also detected only once in Pg (MF381155), which was separated from H6 by 48 mutational steps (Figure 4). The most frequent haplotype, H1, and haplotype H7 were differentiated by only one synonymous mutation (C756T).
The major outcome of our study was the evidence that invasive poaceous species from wheat fields could be an important DMI-resistant fungal inoculum source for the initial phases of a wheat blast epidemic (Urashima & Kato, 1998). Additionally, the invasive poaceous species that is closer to the fungicide-sprayed wheat fields could have an important role as a DMI-resistant inoculum reservoir between cropping seasons.

Figure 3
Alignment of amino acid sequences translated from the CYP51A gene nucleotide sequences obtained from the isolates 12.0.264 (P. grisea), 12.0.625i (P. graminis-tritici), 12.0.358 (P. pennisetigena) and 12.0.224 (P. urashimae), to identify non-synonymous mutations by comparing with the reference sequence of the sensitive isolate 622 (P. oryzae). Haplotypes (H) were represented for each species.

Figure 4
Network of haplotypes of the CYP51A gene from Pyricularia spp. The area of each circle is proportional to the number of isolates sampled from each haplotype. The lines between one circle and another represent the mutational steps between haplotypes.
Three CYP51A haplotypes (H1, H7 and H8) associated with resistance to DMI fungicides were detected among the Pyricularia species that were sampled from several invasive plant species in wheat fields. Castroagudin et al. (2015), who surveyed Pyricularia spp. associated with invasive plants from wheat fields, also detected two of the most common cytB haplotypes (H1 and H3) containing the G143A mutation that confers resistance to the QoI fungicide azoxystrobin. The H1-QoI resistant haplotype was detected in 48% of the isolates from invasive plant species, mostly from signal grass (Urochloa spp.) and weeping finger grass (Chloris distichophylla).
In our study, the number of host plant species harboring DMI-resistant isolates of Pyricularia spp. was high. We detected triazol fungicide-resistant Pyricularia spp. associated with oats (Avena sativa), sandbur (Cenchrus echinatus), weeping finger grass (Chloris distichophylla), star grass (Cynodon spp.), Jamaican crabgrass (D. horizontalis), crabgrass (Digitaria sanguinalis), barnyard grass (Echinochloa crusgalli), Indian goosegrass (Eleusine indica), Guinea grass (Panicum maximum), and signal grass (Urochloa brizantha).
In terms of levels of resistance, with the exception of the rice blast fungus P. oryzae, which was used as our sensitive standard, all of the other four Pyricularia species (Pygt, Pg, Pp, and Pu) associated with invasive Poaceae were resistant to DMI fungicides.
For tebuconazole, the mean EC50 for the four species was 1.18 µg mL-1 (ranging from a minimum of 0.69 to a maximum of 3.56 µg mL-1). These EC50 values for tebuconazole were either similar or lower than the values described in the literature for resistant fungi associated with diseases on wheat or other cereals, which were heavily sprayed with DMI fungicides. Such examples included Mycosphaerella graminicola [maximum EC50 = 0.91 µg mL-1 (Stammler & Semar, 2011)], Rhynchosporium commune [maximum EC50 = 2.00 µg mL-1 (Hawkins et al., 2014) and Zymoseptoria tritici [maximum EC50 = 10.00 µg mL-1 (Cools & Fraaije, 2013).
For epoxiconazole, the mean EC50 for the four Pyricularia species was 0.33 µg mL-1 (with a minimum of 0.10 and a maximum of 0.95 µg mL-1). In comparison with the same wheat or other cereals’ pathogens, the following epoxiconazole EC50 were described: Mycosphaerella graminicola [maximum EC50 = 0.05 µg mL-1 (Stammler & Semar, 2011), Rhynchosporium commune [maximum EC50 = 0.23 µg mL-1 (Hawkins et al., 2014)] and Zymoseptoria tritici [maximum EC50 = 0.48 µg mL-1 (Cools & Fraaije, 2013). Based on the labeled doses of 75 g epoxiconazole ha-1 and 150 g tebuconazole ha-1 recommended for fungicide sprays in Brazilian wheat fields by the Brazilian Ministry of Agriculture, Livestock and Food Supply - MAPA (http://agrofit.agricultura.gov.br/agrofit_cons/principal_agrofit_cons), and using the method proposed by Castroagudin et al. (2015) considering the average wheat plant height at heading stage of approximately 0.82 meters, we estimated that epoxiconazole and tebuconazole are sprayed at the concentrations of 0.0055 µg mL-1 and 0.0180 µg mL-1 per hectare of wheat fields, respectively. Comparing these resulting field concentrations with the mean EC50 values that were estimated, we concluded that, on average, all four Pyricularia species from invasive grasses resisted at 60 to 65 times higher field doses of epoxiconazole or tebuconazole, respectively.
An R158K point mutation in the CYP51A gene that was conserved in four Pyricularia species (Pg, Pp, Pu, and Pygt) but absent in the reference species for DMI sensitivity (Po) may be related to resistance to tebuconazole and epoxiconazole.
In a countrywide population-based study in which 178 Pygt isolates were sampled from seven wheat fields in Brazil, Ceresini et al. (2018) also described the predominance of the R158K mutation in all four DMI-resistant haplotypes detected (H1, H2, H3, and H4). The predominant CYP51A haplotype associated with Pp, Pu and Pygt from invasive species was identical to the H1 haplotype described by (Ceresini et al. 2018), which was the most commonly found in all seven wheat blast populations (N = 175).
However, as reported for few other fungal plant pathogens, in addition to target site mutations found in the CYP51A gene of Pg, Pp, Pu, and Pygt, resistance to DMI fungicides could also be related to other mechanisms of quantitative nature, such as increase in ABC transporter efflux (Nakaune et al., 1998) and overexpression of the CYP51A gene (Ma et al., 2005; Coleman & Mylonakis, 2009; Abou Ammar et al., 2013).
Due to the quantitative and polygenic nature of the resistance attributed to DMI fungicides, the resistance to DMI fungicides found in all four Pyricularia spp. from Poaceae species that are invasive to wheat fields may be a result of slow and gradual selective pressure exerted on the pathogen populations due to long-term use of DMI fungicides at high dosages (Deising, Reimann, & Pascholati, 2008; Lucas et al., 2015).
To avoid the intensification of this scenario over the next few years, the adoption of anti-resistance management strategies is urgently needed. To decrease the selective pressure towards resistant pathogen populations, such strategies would include rotations of fungicides with different modes of action (Milgroom & Fry, 1988) and adoption of mixtures of single-target-site, high-risk fungicides with multiple-target-site, low-risk fungicides (Lucas et al., 2015).
Conclusion
All four Pyricularia species (Pygt, Pg, Pp, and Pu) associated with invasive Poaceae were resistant to DMI fungicides.
Several invasive poaceous species adjacent to sprayed wheat fields constitute an important inoculum reservoir of DMI-resistant Pyricularia spp. for the initial phases of the blast epidemic, especially for wheat blast.
Acknowledgements
This study was funded by FAPESP (São Paulo State Research Foundation, Brazil) research grants to P. C. Ceresini (2013/10655-4, 2015/10453-8 and 2017/50456-1). P.C. Ceresini is supported by research fellowships from Brazilian National Council for Scientific and Technological Development - CNPq (Pq-2 307361/2012-8 and 307295/2015-0). CNPq/UNESP also supported PIBIC stipends to A.F. Dorigan and M.M. Negrisoli. G. Carvalho was supported by a Post-Doctorate research fellowship (PNPD Program) from CAPES (Higher Education Personnel Improvement Coordination, Brazil). N.M. Poloni was supported by an MSc research fellowship from CAPES. We thank CAPES for sponsoring the establishment of the “Centro de Diversidade Genética no Agroecossistema” (Pro-equipamentos 775202/2012).
References
Abou Ammar, G., Tryono, R., Doll, K., Karlovsky, P., Deising, H. B., & Wirsel, S. G. (2013). Identification of ABC transporter genes of Fusarium graminearum with roles in azole tolerance and/or virulence. PLoS ONE, 8(11), e79042. DOI: 10.1371/journal.pone.0079042
Brunner, P. C., Stefanato, F. L., & McDonald, B. A. (2008). Evolution of the CYP51 gene in Mycosphaerella graminicola: evidence for intragenic recombination and selective replacement. Molecular Plant Pathology, 9(3), 305-316. DOI: 10.1111/j.1364-3703.2007.00464.x
Buchenauer, H., & Hellwald, K. H. (1985). Resistance of Erysiphe graminis on barley and wheat to sterol C-14-demethylation inhibitors. EPPO Bulletin, 15(4), 459-466, DOI: 10.1111/j.1365-2338.1985.tb00255.x
Callaway, E. (2016). Devastating wheat fungus appears in Asia for first time. Nature, 532(7600), 421-422. DOI: 10.1038/532421a
Castroagudin, V. L., Ceresini, P. C., De Oliveira, S. C., Reges, J. T., Maciel, J. L., Bonato, A. L., ... McDonald, B. A. (2015). Resistance to QoI fungicides is widespread in Brazilian populations of the wheat blast pathogen Magnaporthe oryzae. Phytopathology, 105(3), 284-94. DOI: 10.1094/PHYTO-06-14-0184-R
Castroagudin, V. L., Moreira, S. I., Pereira, D. A. S., Moreira, S. S., Brunner, P. C., Maciel, J. L. N., … Ceresini, P. C. (2016). Pyricularia graminis-tritici, a new Pyricularia species causing wheat blast. Persoonia, 37(1), 199-216. DOI: 10.3767/003158516x692149
Ceresini, P. C., Castroagudín, V. L., Rodrigues, F. A., Rios, J. A., Aucique-Pérez, C. E., Moreira, S. I., ... Maciel, J. L. N. (2018). Wheat blast: past, present, and future. Annual Review of Phytopathology , 56(1), 20.1-20.30. DOI: 10.1146/annurev-phyto-080417-050036
Clement, M., Posada, D., & Crandall, K. (2000). TCS: a computer program to estimate gene genealogies. Molecular Ecology, 9(10), 1657-1660.
Coleman, J. J., & Mylonakis, E. (2009). Efflux in fungi: la piece de resistance. PLoS Pathogens, 5(6), e1000486. DOI: 10.1371/journal.ppat.1000486
Cools, H. J., & Fraaije, B. A. (2013). Update on mechanisms of azole resistance in Mycosphaerella graminicola and implications for future control. Pest Management Science, 69(2), 150-155. DOI: 10.1002/ps.3348
Crous, P. W., Wingfield, M. J., Burgess, T. I., Hardy, G. E., Crane, C., Barrett, S., … Groenewald, J. Z. (2016). Fungal Planet description sheets: 469-557. Persoonia , 37(1), 218-403. DOI: 10.3767/003158516X694499
Debona, D., Favera, D. D., Corte, G. D., Domingues, L. S., & Balardin, R. S. (2009). Controle químico da ferrugem da folha em cultivares de trigo submetidas a diferentes níveis de adubação nitrogenada. Revista da FZVA, 16(1), 52-65.
Deising, H. B., Reimann, S., & Pascholati, S. F. (2008). Mechanisms and significance of fungicide resistance. Brazilian Journal of Microbiology, 39(2), 286-295. DOI: 10.1590/S1517-838220080002000017
Fan, J., Urban, M., Parker, J. E., Brewer, H. C., Kelly, S. L., Hammond-Kosack, K. E., … Cools, H. J. (2013). Characterization of the sterol 14alpha-demethylases of Fusarium graminearum identifies a novel genus-specific CYP51 function. New Phytologist, 198(3), 821-35. DOI: 10.1111/nph.12193
Hawkins, N. J., Cools, H. J., Sierotzki, H., Shaw, M. W., Knogge, W., Kelly, S. L., ... Fraaije, B. A. (2014). Paralog re-emergence: a novel, historically contingent mechanism in the evolution of antimicrobial resistance. Molecular Biology and Evolution, 31(7), 1793-802. DOI: 10.1093/molbev/msu134
Igarashi, S. (1986). Ocorrência de Pyricularia spp. no estado do Paraná. Fitopatologia Brasileira, 11(2), 351-352.
Islam, M. T., Croll, D., Gladieux, P., Soanes, D. M., Persoons, A., Bhattacharjee, P., ... Kamoun, S. (2016). Emergence of wheat blast in Bangladesh was caused by a South American lineage of Magnaporthe oryzae. BMC Biology, 14(84), 1-11, DOI: 10.1186/s12915-016-0309-7
Jiang, J., Liu, X., Yin, Y., & Ma, Z. (2011). Involvement of a velvet protein FgVeA in the regulation of asexual development, lipid and secondary metabolisms and virulence in Fusarium graminearum. PLoS ONE , 6(11), e28291. DOI: 10.1371/journal.pone.0028291
Lucas, J. A., Hawkins, N. J., & Fraaije, B. A. (2015). The evolution of fungicide resistance. Advances in Applied Microbiology, 90, 29-92. DOI: 10.1016/bs.aambs.09.001
Ma, Z., Yoshimura, M. A., Holtz, B. A., & Michailides, T. J. (2005). Characterization and PCR-based detection of benzimidazole-resistant isolates of Monilinia laxa in California. Pest Management Science , 61(5), 449-457. DOI: 10.1002/ps.982
Maciel, J. L. N. (2011). Magnaporthe oryzae, the blast pathogen: current status and options for its control. Plant Science Review, 6(50), 233-240. DOI: 10.1079/PAVSNNR20116050
Maciel, J. L. N., Ceresini, P. C., Castroagudin, V. L., Zala, M., Kema, G. H., & McDonald, B. A. (2014).Population structure and pathotype diversity of the wheat blast pathogen Magnaporthe oryzae 25 years after its emergence in Brazil. Phytopathology , 104(1), 95-107. DOI: 10.1094/PHYTO-11-12-0294-R
Maciel, J. L. N., Paludo, E. A., Silva, M. S., Scheeren, P. L., & Caierão, E. (2008). Reação à brusone de genótipos de trigo do programa de melhoramento da Embrapa Trigo no estádio de planta adulta. Embrapa Trigo. Boletim de Pesquisa e Desenvolvimento Online, 64, 1-14.
Milgroom, M. G., & Fry, W. E. (1988). A simulation analysis of the epidemiological principles for fungicide resistance management in pathogen populations. Phytopathology , 78(5), 565-570.
Nakaune, R., Adachi, K., Nawata, O., Tomiyama, M., Akutsu, K., & Hibi, T. (1998). A novel ATP-binding cassette transporter involved in multidrug resistance in the phytopathogenic fungus Penicillium digitatum. Applied and Environmental Microbiology, 64(10), 3983-3988.
Navarini, L., & Balardin, R. S. (2012). Doenças foliares e o controle por fungicidas na produtividade e qualidade de grãos de trigo. Summa Phytopathologica, 38(4), 294-299. DOI: 10.1590/S0100-54052012000400004
Pagani, A. P., Dianese, A. C., & Café Filho, A. C. (2014). Management of wheat blast with synthetic fungicides, partial resistance and silicate and phosphite minerals. Phytoparasitica, 42(5), 609-617. DOI: 10.1007/s12600-014-0401-x
Pereira, D. A., McDonald, B. A., & Brunner, P. C. (2016). Mutations in the CYP51 gene reduce DMI sensitivity in Parastagonospora nodorum populations in Europe and China. Pest Management Science , 73(7), 1503-1510. DOI: 10.1002/ps.4486
R Development Core Team. (2011). R: A language and environment for statistical computing. Vienna, AU: R Foundation for Statistical Computing.
Reges, J. T. A., Negrisoli, M. M., Dorigan, A. F., Castroagudin, V. L., Maciel, J. L. N., & Ceresini, P. C. (2016). Pyricularia pennisetigena and P. zingibericola from invasive grasses infect signal grass, barley and wheat. Pesquisa Agropecuária Tropical, 46(2), 206-214. DOI: 10.1590/1983-40632016v4641335
Rozas, J. (2009). DNA sequence polymorphism analysis using DnaSP. Methods in Molecular Biology, 537, 337-350. DOI: 10.1007/978-1-59745-251-9_17
Snelders, E., Karawajczyk, A., Schaftenaar, G., Verweij, P. E., & Melchers, W. J. (2010). Azole resistance profile of amino acid changes in Aspergillus fumigatus CYP51A based on protein homology modeling. Antimicrobial Agents and Chemotherapy, 54(6), 2425-30. DOI: 10.1128/AAC.01599-09
Stammler, G., & Semar, M. (2011). Sensitivity of Mycosphaerella graminicola (anamorph: Septoria tritici) to DMI fungicides across Europe and impact on field performance. EPPO Bulletin , 41(2), 149-155. DOI: 10.1111/j.1365-2338.2011.02454.x
Tormen, N., Lenzii, G., Minuzzi, S., Uebel, J., Cezar, H. S., & Balardin, R. S. (2013). Reação de cultivares de trigo à ferrugem da folha e mancha amarela e responsividade a fungicidas. Ciência Rural, 43(2), 239-246. DOI: 10.1590/S0103-84782013000200008
Urashima, A. S., & Kato, H. (1998). Pathogenic relationship between isolates of Pyricularia grisea of wheat and other hosts at different host developmental stages. Fitopatologia Brasileira , 23(1), p. 30-35.
Vargas, M. H. (2000). ED50plus v1.0. Instituto Nacional de Enfermedades Respiratorias [Computer software]. Mexico, DF, Mexico.
Yan, X., Ma, W. B., Li, Y., Wang, H., Que, Y. W., Ma, Z. H., ... Wang, Z. Y. (2011). A sterol 14alpha-demethylase is required for conidiation, virulence and for mediating sensitivity to sterol demethylation inhibitors by the rice blast fungus Magnaporthe oryzae. Fungal Genetics and Biology, 48(2), 144-53. DOI: 10.1016/j.fgb.2010.09.005
Zhan, J., Stefanato, F. L., & McDonald, B. A. (2006). Selection for increased cyproconazole tolerance in Mycosphaerella graminicola through local adaptation and in response to host resistance. Molecular Plant Pathology , 7(4), 259-68. DOI: 10.1111/j.1364-3703.2006.00336.x
Author notes
* Author for correspondence. E-mail: paulo.ceresini@unesp.br
